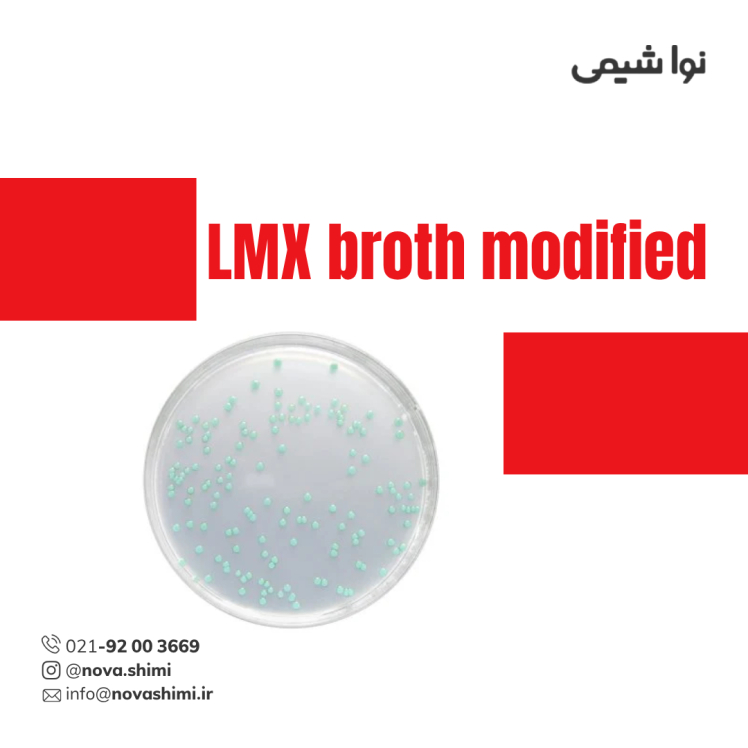
محیط کشت LMX broth مرک (LMX broth modified acc. to MANAFI and OSSMER)

محیط کشت تریپتیک سوی آگار مرک (TSA)
مشخصات فنی محیط کشت YGC Agar:
1. برند: Merck Millipore
2. کاربرد: میکروبیولوژی و کنترل کیفیت باکتریهای هوازی
3. فرم فیزیکی: گرانول خشک (Granulated)
4. حجم بسته: 500 گرم / 5 کیلوگرم / 10 کیلوگرم
محیط کشت TSA چیست؟
محیط کشت Tryptic Soy Agar مرک یک محیط کشت جهانی و بدون مهارکننده است که مناسب برای رشد انواع میکروارگانیسمها و باکتریهای هوازی میباشد. شرکت نُـواشیمی، به عنوان یکی از تامین کنندگان مواد آزمایشگاهی و محیط کشت برند مرک و سیگما آلدریچ، آماده ارائه خدمات فروش محیط کشت YGC Agar مرک کد 116000 به شما عزیزان خواهد بود. برای دریافت اطلاعات فنی و استعلام قیمت محیط کشت وای جی سی آگار مرک، از طریق شماره 02192003669 با کارشناسان فروش نُـوا شیمی تماس حاصل فرمایید.
برای آشنایی بیشتر با ویژگیها و مشخصات محصول، میتوانید با کلیک روی هر عنوان، به توضیحات تکمیلی در زیرعنوانهای مربوطه دسترسی پیدا کنید.
مشخصات محصول (Product Specifications)
مشخصات فنی محیط کشت TSAمرک (Product Specifications)
در جدول زیر میتوانید مشخصات فنی کامل محیط کشت TSA مرک (GranuCult® prime according to EP, USP, JP, ISO and FDA-BAM) را مشاهده کنید.
ویژگی | توضیح |
|---|---|
کد محصول (Cat. No.) | 1.05458 |
برند / تولیدکننده | Merck (Millipore) |
نام تجاری | GranuCult® prime |
فرم فیزیکی | گرانول خشک (Medium granules - dehydrated) |
pH (در 25°C) | 7.1 – 7.5 (40 g/L در H₂O، پس از اتوکلاو) |
حلالیت در آب | 40 g/L |
دانسیتهی تودهای | 620 kg/m³ |
دمای نگهداری | 15–25°C |
مناسب برای | میکروبیولوژی، کنترل کیفیت دارویی |
گواهیها و استانداردها | EP, USP, JP, ISO 11133, FDA (BAM), APHA |
کاربرد اصلی | جداسازی و کشت طیف وسیعی از میکروارگانیسمها، بررسی باکتریهای هوازی |
برای مشاهده اطلاعات کامل محصول در سایت مرک و جزئیات کاربردی آن، بر روی TSA کلیک کنید. شرکت نُـوا شیمی، تأمینکننده انواع محیط کشت برندهای معتبر مانند مرک و سیگما آلدریچ است و امکان خرید آسان و مطمئن این محصولات آزمایشگاهی را برای شما فراهم میکند.
آنالیز و کیفیت (Analysis Note)
ویژگیهای آنالیزی و کیفیت (Analysis Note)
Appearance (clearness): clear to slightly opalescent
Appearance (colour): زرد روشن تا قهوهای روشن
pH-value (25°C, 40 g/L in H₂O, after autoclaving): 7.1 – 7.5
Growth promotion test: مطابق با استانداردهای EP, USP, JP, ISO 11133, FDA (BAM)
Recovery rate: ≥ 70% برای گونههای استاندارد Bacillus subtilis, Escherichia coli, Staphylococcus aureus
عدم رشد میکروارگانیسمهای ناخواسته: مهار باکتریهای معمولی غیر هدف
جدول راهنمای ویژگیهای آنالیزی محیط کشت تریپتیک سوی آگار
ویژگی | توضیح کامل |
|---|---|
شکل ظاهری (Appearance - clearness) | پس از حل شدن در آب و اتوکلاو، محیط کشت شفاف تا اندکی اوپالسنت است که نشاندهنده کیفیت بالای پودر و عدم وجود ذرات معلق است. |
رنگ (Appearance - colour) | رنگ محیط کشت TSA معمولاً زرد روشن تا قهوهای روشن است که ترکیب مناسب پپتونها و شرایط تولید صحیح را نشان میدهد. |
pH-value (25°C, 40 g/L در H₂O) | مقدار pH بین 7.1 تا 7.5 است که شرایط ایدهآل برای رشد باکتریهای هوازی و کنترل کیفیت را فراهم میکند. |
رفتار جامد شدن (Solidification behaviour) | محیط پس از حل شدن و سرد شدن به صورت جامد پایدار درمیآید، که برای رشد بهینه و شمارش کلونیها ضروری است. |
تست رشد (Growth promotion test) | مطابق با استانداردهای EP, USP, JP, ISO 11133 و FDA (BAM) تست میشود تا قابلیت پرورش گونههای استاندارد تضمین شود. |
کلونیهای مرجع (Colony count on reference medium) | تعداد کلونیها پس از تلقیح با گونههای Bacillus subtilis, Escherichia coli, Staphylococcus aureus ثبت میشود تا کارایی محیط بررسی شود. |
درصد بازیابی (Recovery on test medium) | بازیابی ≥70٪ کلونیها نسبت به محیط مرجع نشاندهنده توانایی محیط در حمایت از رشد باکتریهای هوازی است. |
عدم رشد میکروارگانیسمهای ناخواسته | باکتریهای غیر هدف یا آلودگیهای ناخواسته در این محیط رشد نمیکنند، که نشاندهنده اثر انتخابی محیط است. |
دمای انکوباسیون (Incubation) | محیط برای رشد باکتریهای هوازی در 35 ± 1°C به مدت 24–48 ساعت انکوبه میشود. |
خرید محیط کشت TSA مرک (GranuCult®Tryptic Soy Agar)
خرید محیط کشت TSA مرک (GranuCult® Tryptic Soy Agar) مرک کد 105458
محیط کشت TSA مرک یک محیط کشت جهانی و همهمنظوره است که برای جداسازی و کشت طیف وسیعی از باکتریهای هوازی طراحی شده است. این محیط بدون مهارکننده یا شاخص است و با ترکیب دو پپتون از پروتئین کازئین و سویا، منابع غنی از نیتروژن، اسیدهای آمینه و پپتیدهای زنجیرهبلند را فراهم میکند. کلرید سدیم موجود تعادل اسمزی محیط را حفظ میکند و آگار به عنوان عامل جامدکننده عمل میکند.
محیط کشت TSA مرک با کیفیت بالای گرانیولهای GranuCult® prime، قابلیت پشتیبانی از رشد سریع و مطمئن باکتریها را دارد و برای استفاده در میکروبیولوژی و کنترل کیفیت محصولات دارویی ایدهآل است. این محیط، با استانداردهای EP، USP، JP، ISO 11133 و FDA (BAM) مطابقت دارد و توانایی بالایی در بازیابی گونههای مرجع دارد.
کمپانی مِرک (MERCK)
شرکت مرک (Merck KGaA) یکی از قدیمیترین و معتبرترین کمپانیهای علمی و فناوری در جهان است که در سال 1668 در آلمان تأسیس شد و امروزه بهعنوان پیشگام جهانی در حوزههای مواد شیمیایی آزمایشگاهی، بیوتکنولوژی و داروسازی شناخته میشود. بخش مواد آزمایشگاهی مرک، طیف گستردهای از مواد شیمیایی با گریدهای مختلف از جمله آنالیتیکال، ACS، HPLC، و Suprapur® را ارائه میدهد که برای تحقیقات علمی، کنترل کیفیت صنعتی، و مصارف آموزشی کاربرد دارند.
شرکت نُـوا شیمی، تامین کننده مواد آزمایشگاهی محیط کشت
شرکت نُـوا شیمی، با سابقهای درخشان در تامین مواد آزمایشگاهی، استاندارد ها و تجهیزات آزمایشگاه، با دسترسی گسترده به محصولات برندهای معتبر داخلی و بینالمللی، تامین نیازهای صنایع، آزمایشگاههای تحقیقاتی و داروسازی را با رویکردی مدرن و دقیق دنبال میکند. در صورت نیاز به استعلام قیمت محیط کشت TSA مرک کد 105458 یا سایر مواد آزمایشگاهی، استاندارد و رفرنسهای آزمایشگاهی کارشناسان ما از طریق خط ویژه 02192003669 آماده پاسخگویی و ارائه مشاوره تخصصی به شما خواهند بود.
کاربرد های محیط کشت تریپتیک سوی آگار (TSA)
مهمترین کاربردهای محیط کشت TSA:
در ادامه، کاربردهای محیط کشت تریپتیک سوی آگار مرک را مطالعه خواهیم نمود:
1. میکروبیولوژی عمومی
محیط کشت تریپتیک سوی آگار یک محیط کشت همهمنظوره است که برای رشد و پرورش باکتریهای هوازی و میکروارگانیسمهای غیرانتخابی مناسب است. این محیط، به دلیل ترکیب غنی پپتونها و کلرید سدیم، رشد سریع و مطمئن گونههای باکتریایی را تضمین میکند و برای آزمایشگاههای میکروبیولوژی ضروری است.
2. کنترل کیفیت دارویی
محیط کشت TSA مرک در صنایع دارویی برای بررسی میکروبی محصولات و کنترل کیفیت باکتریهای هوازی استفاده میشود. این محیط توانایی بازیابی کلونیهای مرجع مانند Bacillus subtilis و Escherichia coli را دارد و برای تایید سلامت میکروبی محصولات مناسب است.
3. تحقیق و توسعه
در بخشهای تحقیقاتی و علمی، محیط کشت تریپتیک سوی آگار برای کشت نمونههای بالینی، محیطهای غذایی و نمونههای دارویی استفاده میشود. این محیط به محققان امکان میدهد تا رفتار و رشد گونههای مختلف باکتری را به صورت دقیق بررسی کنند.
4. شناسایی میکروارگانیسمها
استفاده از محیط کشت TSA به شناسایی میکروارگانیسمهای هوازی کمک میکند. رشد واضح کلونیها و قابلیت بازیابی بالای گونههای استاندارد باعث میشود تا محیط برای تشخیص و مطالعه میکروارگانیسمها بسیار مناسب باشد.
5. پرورش باکتریهای صنعتی
محیط کشت تریپتون سوی آگار در صنایع غذایی و بیوتکنولوژی برای پرورش باکتریهای مفید و بررسی فعالیت میکروبی محصولات مورد استفاده قرار میگیرد. این محیط با فراهم کردن تغذیه مناسب و شرایط رشد پایدار، به تولید کلونیهای سالم و قابل بررسی کمک میکند.
برای دریافت استعلام قیمت محیط کشت TSA مرک کد 105458، لطفا با شماره 02192003669 تماس حاصل فرمایید. کارشناسان ما آماده پاسخگویی به سوالات شما هستند.
نکات ایمنی
نکات ایمنی و نگهداری (Safety & Storage)
در ادامه نکات ایمنی استفاده از محیط کشت TSA مرک ( GranuCult® Tryptic Soy Agar) برند مرک را مطالعه خواهیم نمود:
مورد | توضیح |
|---|---|
کلاس ذخیرهسازی | 11 – Combustible Solids |
WGK (Water hazard class) | 1 |
شرایط نگهداری | در محیط خشک، دمای 15–25°C، دور از نور مستقیم |
احتیاط | از تماس با پوست و استنشاق گرد و غبار خودداری شود. هنگام آمادهسازی و کار با محیط، از دستکش و ماسک استفاده شود. محیط باید در محیط دارای تهویه مناسب کار شود. |
اگر به دنبال محیط کشت تریپتیک سوی آگار (GranuCult®Trypton Soya Agar) هستید، نُـوا شیمی همراهی مطمئن در مسیر تامین نیاز های شما خواهد بود. برای سفارش، دریافت مشاوره فنی و آگاهی از شرایط همکاری؛ از طریق شماره 02192003669 با تیم فروش در ارتباط باشید.
سوالات متداول (FAQ)
سوالات متداول درباره محیط کشت تریپتیک سوی آگار مرک (FAQ)
1. محیط کشت TSA مرک برای چه نوع میکروارگانیسمهایی مناسب است؟
محیط کشت TSA برای رشد و جداسازی باکتریهای هوازی و میکروارگانیسمهای غیرانتخابی طراحی شده است و توانایی بازیابی گونههای مرجع را دارد.
2. آیا محیط کشت تریپتیک سوی آگار حاوی مهارکننده یا شاخص است؟
خیر، این محیط بدون مهارکننده یا شاخص است و به همین دلیل یک محیط کشت همهمنظوره برای طیف گستردهای از باکتریها محسوب میشود.
3. چه استانداردهایی را محیط کشت TSA مرک پشتیبانی میکند؟
این محیط مطابق با استانداردهای EP، USP، JP، ISO 11133 و FDA (BAM) تولید شده و کیفیت بالای گرانیولهای GranuCult® prime را تضمین میکند.
4. شرایط نگهداری محیط کشت تریپتیک سوی آگار چگونه است؟
محیط باید در محیط خشک و خنک (15–25°C) نگهداری شود و از تماس با رطوبت و نور مستقیم محافظت گردد.
5. مدت زمان نگهداری محیط کشت پس از آمادهسازی چقدر است؟
پس از آمادهسازی، محیط کشت TSA مرک برای مدت طولانی پایدار است و رشد مطلوب باکتریها را حفظ میکند، به ویژه اگر به درستی در ظروف استریل و بستهبندی مناسب نگهداری شود.
6. آیا میتوان از این محیط برای کنترل کیفیت محصولات دارویی استفاده کرد؟
بله، محیط کشت TSA در آزمایشگاههای کنترل کیفیت دارویی برای بررسی میکروبی محصولات و بازیابی کلونیهای باکتری استاندارد مانند Bacillus subtilis و Escherichia coli کاربرد دارد.

هنوز نظری ثبت نشده
اولین نفری باشید که نظر میدهید
ثبت نظر